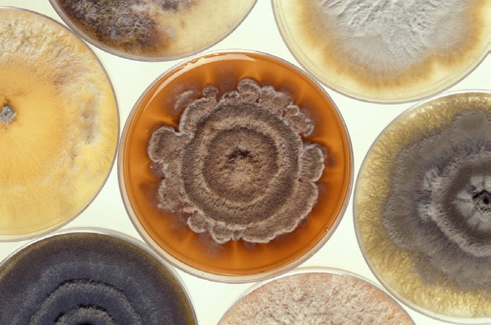

Мы приняли вашу заявку, свяжемся с вами в ближайшее время.

История
Часть товаров из корзины будет перемещена в статус отложенных и не сможет быть оформлена для заказа, если вы продолжите работу в данном регионе
История

История
История
Для контроля качества и безопасности сырья и готовой пищевой продукции часто требуется анализировать содержание микотоксинов, а также аминокислотный состав.
Микотоксины – это вторичные метаболиты микроскопических (плесневых) грибов, которые обитают на многих сельскохозяйственных культурах. Микотоксины являются токсичными соединениями, способными вызывать острые отравления человека и животных, включая летальные исходы. При систематическом приеме корма, зараженного микотоксинами, у животных развиваются хронические заболевания, снижающие их продуктивность и репродуктивный потенциал (вплоть до стерильности). Издержки, связанные с лечением и заменой выбывших животных, снижают экономический эффект сельскохозяйственного производства.
Описаны сотни микотоксинов различной степени токсичности. Наиболее опасными и хорошо изученными являются: афлатоксины (B1, B2, G1, G2, M1, M2), охратоксин А, фумонизины (B1, B2), трихотецены (Т-2, НТ-2, дезоксиниваленол), зеараленон, монилиформин. Концентрации большинства перечисленных микотоксинов в сырье, кормах и пищевых продуктах контролируются в России и странах ЕАЭС. Например, предельно допустимые концентрации (ПДК) указаны в Технических регламентах Таможенного союза (ТР ТС): ТР ТС 015/2011 «О безопасности зерна», ТР ТС 021/2011 «О безопасности пищевой продукции», ТР ТС 033/2013 «О безопасности молока и молочной продукции» и пр.

|

|

|
|
Aflatoxin B1 |
Aflatoxin G1 |
Aflatoxin M1 |

|

|

|
|
Aflatoxin B2 |
Aflatoxin G2 |
Aflatoxin M2 |
Структурные формулы афлатоксинов B1, B2, G1, G2, M1, M2
Самым точным методом для выявления микотоксинов в зерне и продуктах питания является высокоэффективная жидкостная хроматография (ВЭЖХ). Комплектация и параметры хроматографических систем подбираются исходя из конкретного анализируемого микотоксина. В качестве примера рассмотрим количественное выявление афлатоксинов при помощи ВЭЖХ.
Афлатоксины продуцируются грибами рода Aspergillus, в основном видами Aspergillus flavus и Aspergillus parasiticus. Данные грибы загрязняют афлатоксинами до четверти всех посевов в мире. Эти метаболиты устойчивы в окружающей среде, в том числе термостабильны и не разрушаются после пастеризации. Наиболее опасен афлатоксин В1, который относится к канцерогенам первой группы. Его обнаруживают, например, в зерне, арахисе, фисташках, семенах хлопчатника, сушеных фруктах и прочих переработанных продуктах. Афлатоксины B2, G1, G2 встречаются наряду с В1, но в гораздо меньших концентрациях. При употреблении коровами в пищу зараженных кормов, в их организме афлатоксины B1 и B2 метаболизируются в афлатоксины M1 и M2, которые накапливаются в коровьем молоке и представляют опасность для употребляющих молочные продукты, особенно для детей.

Фотохимическая активация (гидроксилирование) афлатоксина В1

Для выявления афлатоксинов применяют флуоресцентную детекцию. Однако у афлатоксинов B1 и G1 слишком низкий уровень флуоресценции. При облучении смеси афлатоксинов ультрафиолетовым светом (УФ) с длиной волны 254 нм афлатоксины B1 и G1 подвергаются фотоиндуцированному гидроксилированию, после чего их концентрации могут быть определены с помощью флуоресцентной спектрометрии. Таким образом, хроматографическая система требует постколоночной дериватизации.
В качестве примера приводим конфигурацию системы ВЭЖХ EClassical 3200 китайской компании Dalian Elite Analytical Instruments для выявления афлатоксинов:

Аминокислотный состав продуктов очень важен для понимания пищевой ценности, соблюдения диетических рекомендаций, составления правильных рационов питания животных и пр. Аминокислоты – это одни из самых сложных объектов для анализа при помощи ВЭЖХ из-за их разнообразия, сложной структуры и отсутствия реакции на УФ- и флуоресцентное облучение.
Анализ аминокислот выполняется в два этапа. Первым является гидролиз аминокислот. Обычно предпочтительным методом является кислотный гидролиз. Второй этап – это предколоночная дериватизация, разделение и детекция продуктов реакции. Для дериватизации используются различные химические реагенты. Наиболее популярные: 1-фтор-2,4-динитробензол (DNFB), ортофталевый альдегид (ОРА), 6-аминохинолил-N-гидроксисукцинимидилкарбамат (AQC). Последний реагент обращает на себя особое внимание, поскольку имеет ряд преимуществ перед аналогами. Так, AQC – это высоко активное соединение, взаимодействующее с аминокислотами с образованием стабильных производных мочевины, которые легко поддается анализу при помощи обращенно-фазовой ВЭЖХ. Первичные и вторичные аминокислоты быстро дериватизируются и остаются стабильны более семи дней при комнатной температуре. При использовании других реагентов, например, OPA, некоторые аминокислоты стабильны всего несколько минут. Еще одной сильной стороной AQC является то, что его дериваты обнаруживаются при помощи УФ-детекции. Это, например, позволяет с высокой чувствительностью количественно определять триптофан, который не выявляется при флуоресцентном обнаружении аддуктов ОРА.
Один из вариантов конфигурации системы ВЭЖХ EClassical 3200 для детекции аминокислот включает в себя:

|

|
|
Схема взаимодействия 6-аминохинолил-N-гидроксисукцинимидилкарбамата (AQC) с первичной либо вторичной аминокислотой с образованием деривата аминокислоты
|
Хроматограмма разделения аминокислот молока |
Обращаем ваше внимание, что приведенные конфигурации EClassical 3200 для детекции микотоксинов и аминокислот носят предварительный характер. Детальный список необходимого оборудования сотрудники Диаэм составят исходя из конкретных условий и потребностей пользователя (анализируемые объекты, планируемые к использованию методы, реактивы и пр.).
|
ECl3200-Q-DAD_компл
|
|
|
|
По запросу По запросу |
|
|
|
|||||
|
Китайские производители во многих отраслях приборостроения (в том числе ВЭЖХ) представляют системы ничуть не хуже привычных нам «топовых» европейских и американских производителей. Это утверждение более чем верно для системы ВЭЖХ EClassical 3200. ВЭЖХ система обычно состоит из четырех основных частей (модулей): насос, система ввода образца (ручная или автосамплер), термостат колонки и детектор. Каждая ВЭЖХ система собирается под конкретную аналитическую задачу (или список аналитических задач) клиента. Многообразие сочетаний модулей позволяет построить гибкую систему под любые задачи лаборатории. Основные технические характеристики системы EClassical 3200Насос
Автосамплер
Термостат колонок
Диодно-матричный детектор
УФ-детектор
|
||||||||||||
|
|
||||||||||||
См. также:
Анализаторы аминокислот и витаминов
Колонки, предколонки и сорбенты для жидкостной хроматографии
Фильтрующие вакуумные системы для ВЭЖХ
Хроматографы жидкостные среднего давления
Хроматографы жидкостные низкого давления
Хроматография пробоподготовка: фильтрация, ТФЭ и экстракция под давлением
Экстракция твердофазная (под давлением, вакуумная)
С помощью личного кабинета Вы сможете:
Сравнение